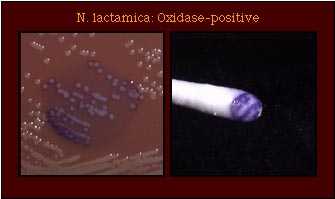
oxidase

Neisseria lactamica
Introduction
N. lactamica was described by Hollis et al. in 1969 and as N. meningococcoides by Berger in 1970.
Strains of N. lactamica had not been described in studies previous to 1969 because acid production from lactose was not used as a differential test for the identification of Neisseria spp. Prior to the description of this species, strains of N. lactamica would have been identified as N. meningitidis.
N. lactamica strains are colistin-resistant, grow on gonococcal selective medium, and are characterized by their ability to produce acid from glucose, maltose, and lactose, and by their ability to produce beta-galactosidase. Among the Neisseria species, N. lactamica is the probably the easiest species to identify; it is the only species that produces acid from lactose and produces beta-galactosidase. Thus, with a rare exception (one known, unpublished report of a lactose-negative strain), this species should not be misidentified.
N. lactamica is isolated frequently from children but infrequently from from adults.
Table 1. Characteristics of N. lactamica
| Characteristic | Illustration |
|---|---|
| Gram stain Cell Morphology | Gram-negative diplococcus |
| Colony Morphology | ![]() |
| Pigmentation | ![]() |
| Oxidase Test | ![]() |
Most strains of N. lactamica produce acid from lactose. One strain is known to be lactose-negative; this strain, however, produced beta-galactosidase in an enzyme substrate test |
|
| enzyme substrate test | Beta-galactosidase (ONPG)-positive |
| Nitrate Reduction Test | Nitrate -ve |
| Polysaccharide from Sucrose | ![]() Polysaccharide -ve |
| Production of Deoxyribonuclease (DNase) | ![]() DNase -ve |
| Superoxol Test (Reaction with 30% hydrogen peroxide) | ![]() Weak (1+) to Strong (3+) Reactions |
| Catalase Test (Reaction with 3% hydrogen peroxide) | ![]() Catalase-positive |
| Colistin Resistance | ![]() Colistin-resistant |
Neisseria species which may be misidentified as N. lactamica
Among the Neisseria species, N. lactamica is the probably the easiest species to identify. N. lactamica is the only species that produces acid from lactose and beta-galactosidase. Thus, with a rare exception (one known, unpublished report of a lactose-negative strain), this species should not be misidentified. An identification of N. lactamica may be confirmed by detection of beta-galactosidase in an enzyme substrate test.
References
Bovre K. 1984. Family VIII. Neisseriaceae Prevot, p. 288-309. In N. R. Krieg (ed.). Manual of Systematic Bacteriology, vol. 1. The Williams & Wilkins co., Baltimore.
Knapp, J. S. 1988. Historical perspectives and identification of Neisseria and related species. Clin. Microbiol. Rev. 1:415-431.
Knapp JS, Rice RJ. Neisseria and Branhamella. In. Murray PR, Baron EJ, Pfaller MA, Tenover FC, Yolken RH. (ed.). Manual of Clinical Microbiology. 6th ed. American Society for Microbiology, Washington D. C, 1995.
Vedros NA. 1984. Genus I. Neisseria Trevisan 1885, 105AL, p. 290-296. In N. R. Krieg (ed.). Bergey's Manual of Systematic Bacteriology, vol. 1. The Williams & Wilkins Co., Baltimore.
- Page last reviewed: March 31, 2017
- Page last updated: October 17, 2008
- Content source:
ShareCompartir